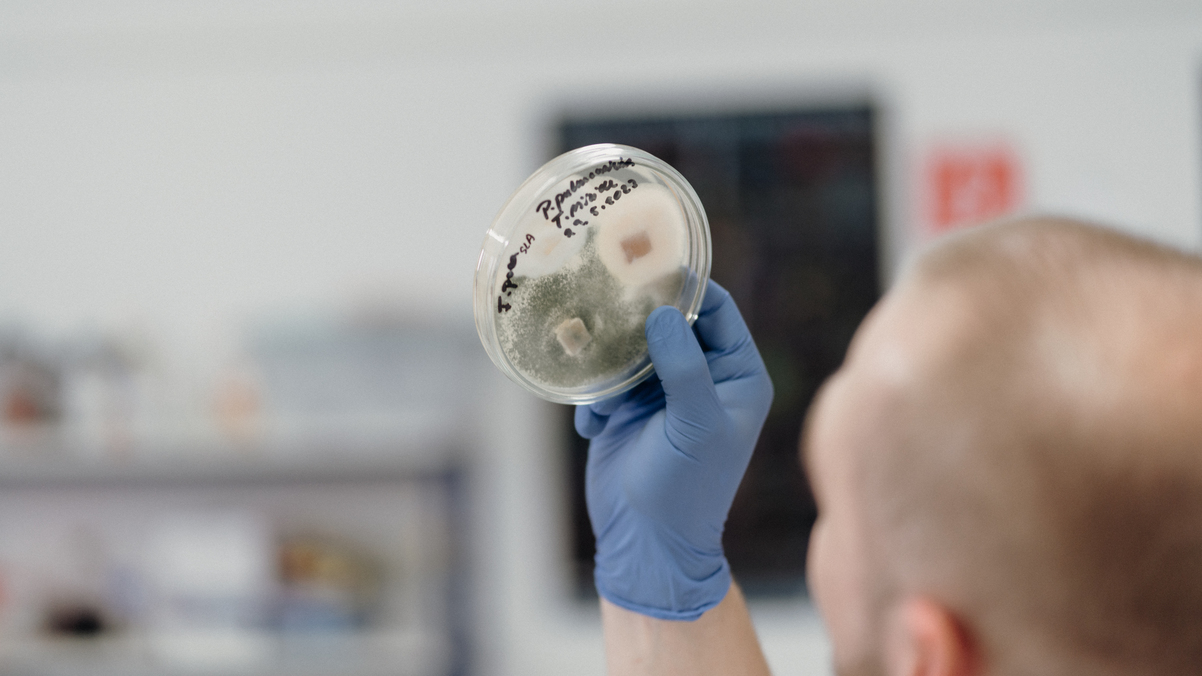

Biotechnológie (Mgr.)
- Študijný odbor: biotechnológie
- Forma štúdia: DENNÁ
- Stupeň štúdia: 2., magisterský
- Dĺžka štúdia: 2 roky
- Vyučovací jazyk: slovenčina
- Úroveň národného kvalifikačného rámca: 7
Študenti študijného programu biotechnológie má v čase ukončenia nasledujúce teoretické vedomosti, praktické schopnosti a zručnosti:
- Nadobudne primerané poznatky zo základných prírodovedeckých disciplín, hlavne biotechnológií, biológie a chémie, ako aj ich hraničných oblastí. Vzhľadom na skutočnosť, že program zapadá do študijného odboru Biotechnológie ide predovšetkým o predmety akcentujúce biotechnologické aspekty. Významnou obsahovou časťou štúdia popri klasických chemických a biologických predmetoch je dôraz.
- Na biotechnologické disciplíny ako sú priemyselné biotechnológie, nanobiotechnológie, molekulárne biotechnológie, ale aj moderné biologické disciplíny, ktoré sú základom pre moderné biotechnológie, ako sú molekulárno-biologické techniky, inštrumentálne metódy analýzy, biopalivá a produkty z obnoviteľných zdrojov, nové a funkčné potraviny a iné.
- Nadväznosť na ekologické aj environmentálne disciplíny a predmety zahrňujúce problematiku trvale udržateľného rozvoja v úzkej väzbe na regionálne špecifiká.
Vzhľadom na širšiu uplatniteľnosť absolventa v praxi je prírodovedný a technologický základ štúdia doplnený o vybrané legislatívno-právne, etické a manažérske disciplíny. Štúdium v druhom stupni súčasne vytvára predpoklady pre pokračovanie v treťom stupni štúdia.
Študenti študijného programu biotechnológie má v čase ukončenia nasledujúce teoretické vedomosti, praktické schopnosti a zručnosti:
- Získavajú návyky pre definovanie vedeckých hypotéz, prípravu projektov (experimentálnych) na ich overenie, experimentálne riešenie, definovanie výstupov a ich charakterizovanie, prezentovanie, obhajovanie a realizovanie (i v praxi).
- Absolventi magisterského štúdia majú teoretické vedomosti o štruktúrach prokaryotických aj eukaryotických biologických systémov a podstate procesov (fyzikálno-chemických, biochemických a fyziologických) prebiehajúcich v nich ako aj o mechanizmoch ich regulácie. Získavajú prehľad o nich a vedia ich aplikovať v praxi. Poznajú metódy zásahov do genómu prokaryotických a eukaryotických buniek, princípov genetickej modifikácie organizmov, spôsoby charakterizovania genetických zmien a získavajú prehľad o využívaní geneticky modifikovaných organizmov v rôznych oblastiach praxe.
- Sú schopní vykonávať prípravu biologických systémov k ich praktickému využitiu a samostatne riešiť (riadiť) dielčie operácie súvisiace s ich cieleným využívaním v poľnohospodárskopotravinárskej, farmaceuticko-medicínskej a chemicko-environmentálnej oblasti.
- Majú dostatok teoretických vedomostí a praktických skúseností potrebných k vykonávaniu laboratórnej kontroly a vyhodnocovaniu získaných údajov a vedia komunikovať s ekvivalentným stupňom manažmentu.
- Vlastnia vedomosti o ekonomických, právnych, etických a environmentálnych aspektoch biotechnológií, ktoré im umožňujú uplatniť sa na strednom stupni funkčných činností vo vedeckovýskumnej, výrobno-podnikateľskej sfére.
Absolvent/ka študijného programu je odborník, ktorý nachádza uplatnenie v rozličných oblastiach spoločenskej praxe. Získa poznatky z biotechnológii a príbuzných oblasti (najmä biologických, chemických, genetických a ich špecializácií) podmieňujúcich rozvoj biotechnológií najmä v oblastiach tzv. bielych, zelených a červených biotechnológií. Dokáže sa zapojiť do výskumu, vývoja a inovácií smerujúcich najmä do priemyslu, poľnohospodárstva, zdravotníctva, životného prostredia, energetiky, ako aj uplatniť svoje vedomosti priamo vo výrobnej praxi v týchto oblastiach.
- sú schopní skúmať biomolekuly a biologické systémy, ako aj ich prakticky využiť
- vedia samostatne riadiť jednotlivé operácie súvisiace s ich cieleným využívaním v poľnohospodársko-potravinárskej, farmaceuticko-medicínskej a chemicko - environmentálnej oblasti, ako aj v oblasti priemyselného využitia obnoviteľných surovín
- majú dostatok teoretických vedomostí a praktických skúseností potrebných k vykonávaniu laboratórnych ale aj výrobných činností a vyhodnocovaniu získaných údajov a vedia komunikovať s ekvivalentným stupňom manažmentu
- majú tiež vedomosti o ekonomických, právnych, etických a environmentálnych aspektoch biotechnológií, ktoré im umožňujú uplatniť sa na strednom stupni funkčných činností vo vedeckovýskumnej, ale aj vo výrobno-podnikateľskej sfére.
- vedecko-výskumný pracovník
- laboratórny diagnostik
- laborant na rôznych oddeleniach (biochémia, mikrobiológia a pod.)
- produktový špecialista
- operátor chemickej výroby
- pracovník príjmu suroviny
- pracovník výroby kvasiar/destilatér
- technik výroby
- kontrolór kvality
- špecialista vo výskume a vývoji
- technológ
- agronóm
- špecialista sanitácie a hygieny
Podmienky prijatia pre DENNÚ a EXTERNÚ formu štúdia.
Požiadavky na uchádzačov, spôsob výberu a odporúčaných osobnostných predpokladov
Počet študentov prijímaných na študijný program: 30
Základnou podmienkou prijatia na štúdium študijného programu druhého stupňa je absolvovanie študijného programu prvého stupňa (podľa § 56 ods. 2 zákona č. 131/2002 Z. z. o vysokých školách a o zmene a doplnení niektorých zákonov).
Prijímacie konanie prebieha bez prijímacej skúšky.
Pri prijímaní na zvolený študijný program sa berie do úvahy skutočnosť, či uchádzač skončil študijný program na FPV UCM v Trnave alebo na inej vysokej škole príbuzného zamerania. Pri prijímaní do magisterského študijného programu sa hodnotí výsledok bakalárskeho štúdia. V prípade uchádzačov z iných fakúlt a absolvovania bakalárskeho štúdia v príbuzných odboroch sa hodnotí aj skladba absolvovaných predmetov v prvom stupni štúdia. V prípade absolvovania bakalárskeho štúdia v príbuzných odboroch môže prijímacia komisia FPV požadovať vykonanie prijímacích skúšok. Viac informácií tu.
Máte otázky k študijnému programu? Opýtajte sa jeho hlavného garanta
: jan.kraic@ucm.sk
spolugaranti